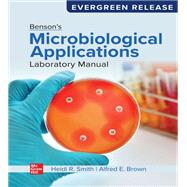
Book cover for Benson's Microbiological Applications Laboratory Manual: 2025 Release

Benson's Microbiological Applications Laboratory Manual: 2025 Release
Benson's Microbiological Applications Laboratory Manual: 2025 Release
- ISBN 13: 9781264585106
- ISBN 10: 1264585101
- Format: Hardcover
- Copyright: 02/09/2021
- Publisher: McGraw-Hill Higher Education (US)
List Price $224.67 Save
| TERM | PRICE | DUE |
|---|---|---|



List Price $224.67 Save $2.24
Usually Ships in 3-4 Business Days
We Buy This Book Back!
Free Shipping On Every Order
Note: Supplemental materials are not guaranteed with Rental or Used book purchases.
Need to keep your rental past your due date? At any time before your due date you can extend or purchase your rental through your account.






